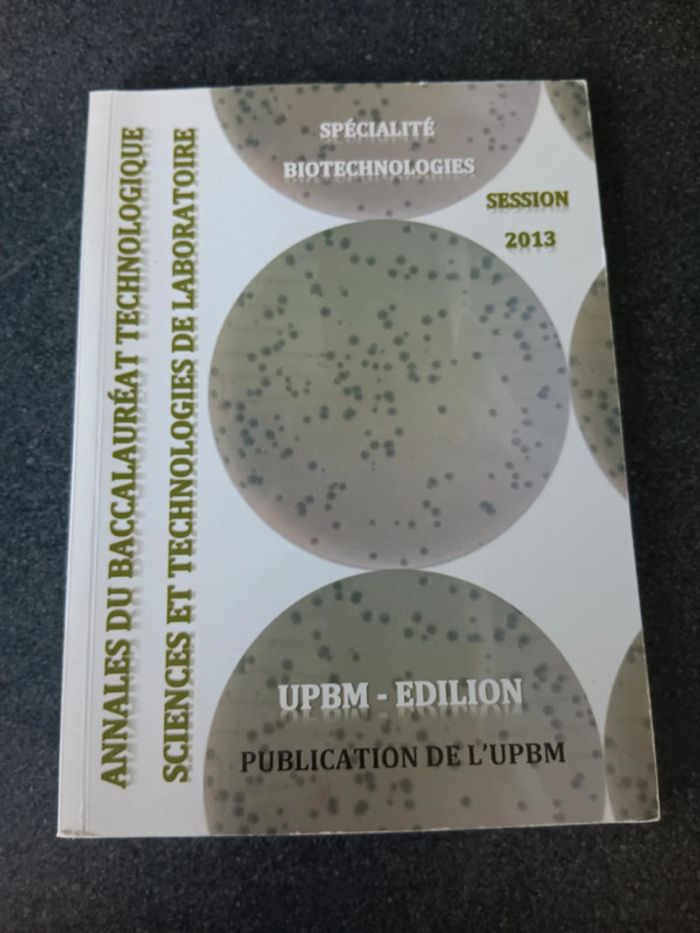

Sur l’appli, il y a des réducs exclusives, des points fidélité et d’autres surprises !
Découvrir Beebs by KiabiMode AdulteMode EnfantPuéricultureJeux & JouetsConsolesMaison
Notre Sélection
Marques
Paiement et livraison sécurisés
Livraison en points relais
42 000 points relais
+ de 6 millions d’articles en vente
À votre écoute 7j/7